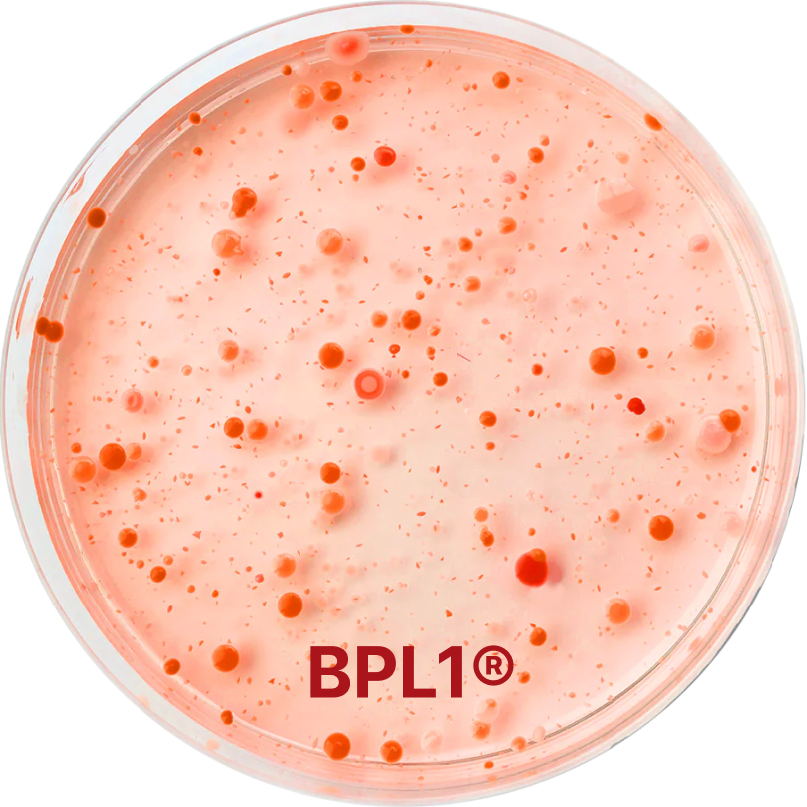

Stomach Guard
GUT+ is not your typical probiotic. Why is it better than any other probiotics out there in the market today? Well, there are several.
GUT+ Probiotic has inactivated cells that can handle harsh stomach conditions and not affected by temperature or PH level. Its survival is highly independent in the stomach and specifically bind or ‘lock’ to Helicobacter pylori in the stomach and then exert or ‘flush’ them out without disturbing normal gut microbial balance. It works on reducing inflammation at stomach lining thus improving gastrointestinal symptoms.
GUT+ Probiotic is a single-strain probiotic that shows strong and positive supporting clinical evidence. It features rigorously validated single-strain probiotic which provide you the best result for maintaining a healthy gut.